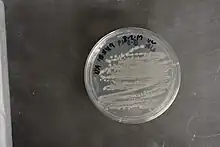

Priestia
| Priestia | |
|---|---|
![]() | |
| Priestia megaterium | |
| Scientific classification | |
| Domain: | |
| Phylum: | |
| Class: | |
| Order: | |
| Family: | |
| Genus: | Priestia Gupta et al. 2020 |
| Species | |
Information based on LPSN 2021 | |
Priestia is a genus of mostly Gram-positive (P. flexa stains Gram-variable and P. koreensis stains Gram-negative), rod-shaped bacteria in the family Bacillaceae from the order Bacillales.[1][2] The type species of this genus is Priestia megaterium.[3]
Members of Priestia are previously species belonging to Bacillus, a genus that has been recognized as displaying extensive polyphyly within its members due to the vague criteria[4] used to assign species to this clade. Multiple studies have been conducted using comparative phylogenetic analyses as a means to clarify the evolutionary relationships between Bacillus species, resulting in the transfer of species into numerous novel genera such as Alkalihalobacillus, Brevibacillus, Solibacillus, Alicyclobacillus, Virgibacillus and Evansella.[5][6][7][8][9][1] In addition, the genus Bacillus has been restricted to only include species closely related to Bacillus subtilis and Bacillus cereus.[5][1]
Priestia is named after the British microbiologist Fergus G. Priest (professor, Heriot-Watt University, Edinburgh; 1948–2019) for his many contributions to the systematics and uses of the members of the genus Bacillus.[1]
Biochemical characteristics and molecular signatures[1]
Members of this genus are aerobic and found in diverse locations, such as soil, faeces, upper atmosphere, inner tissues of cotton plants, sea sediment, and the rhizosphere of willow roots. All members can produce endospores and most are motile. Priestia species can grow in temperatures ranging from 5 to 48 °C, with optimal growth in the range of 28–37 °C, so it can be qualified as a mesophile and psychrotrophic organism. P. aryabhattai is industrially important as it is resistant to arsenic and UV radiation, allowing for an affordable alternative to conventional, expensive, metal remediation technologies.
Two conserved signature indels (CSIs) have been identified through genomic analysis as exclusive for this genus in the proteins oligoribonuclease NrnB or cAMP/cGMP phosphodiesterase and DHH superfamily protein, and can be used to reliably differentiate this genus from other Bacillaceae genera and bacteria in molecular terms.[1]
Taxonomy
Priestia, as of May 2021, contains 10 species with validly published names.[3] This genus was identified as a monophyletic clade and phylogenetically unrelated to other Bacillus species in studies examining the taxonomic relationships within Bacillus.[1] This branching pattern is also observed in the Genome Taxonomy Database.[10]
Two invalidly published species, "Bacillus pseudoflexus" and "Bacillus zanthoxyli", are also found to group with other members of Priestia in phylogenetic trees, as well as share the same molecular markers in the form of CSIs.[1] Their transfer was not officially proposed, though, due to the lack of culture strain information. Further revision of this genus is required, as additional genomes and novel species are discovered and assigned.
References
- 1 2 3 4 5 6 7 8 Gupta, Radhey S.; Patel, Sudip; Saini, Navneet; Chen, Shu (1 November 2020). "Robust demarcation of 17 distinct Bacillus species clades, proposed as novel Bacillaceae genera, by phylogenomics and comparative genomic analyses: description of Robertmurraya kyonggiensis sp. nov. and proposal for an emended genus Bacillus limiting it only to the members of the subtilis and cereus clades of species". International Journal of Systematic and Evolutionary Microbiology. 70 (11): 5753–5798. doi:10.1099/ijsem.0.004475. ISSN 1466-5026. PMID 33112222.
- ↑ Brenner, Don J.; Krieg, Noel R.; Staley, James T.; Garrity, George M.; Boone, David R.; De Vos, Paul; Goodfellow, Michael; Rainey, Fred A.; Schleifer, Karl-Heinz, eds. (2005). Bergey's Manual® of Systematic Bacteriology. doi:10.1007/0-387-28022-7. ISBN 978-0-387-24144-9.
- 1 2 "Genus: Priestia". lpsn.dsmz.de. Retrieved 30 May 2021.
- ↑ Ash, Carol; Farrow, J.A.E.; Wallbanks, Sally; Collins, M.D. (28 June 2008). "Phylogenetic heterogeneity of the genus Bacillus revealed by comparative analysis of small-subunit-ribosomal RNA sequences". Letters in Applied Microbiology. 13 (4): 202–206. doi:10.1111/j.1472-765x.1991.tb00608.x. ISSN 0266-8254. S2CID 82988953.
- 1 2 Patel, Sudip; Gupta, Radhey S. (1 January 2020). "A phylogenomic and comparative genomic framework for resolving the polyphyly of the genus Bacillus: Proposal for six new genera of Bacillus species, Peribacillus gen. nov., Cytobacillus gen. nov., Mesobacillus gen. nov., Neobacillus gen. nov., Metabacillus gen. nov. and Alkalihalobacillus gen. nov". International Journal of Systematic and Evolutionary Microbiology. 70 (1): 406–438. doi:10.1099/ijsem.0.003775. ISSN 1466-5026. PMID 31617837.
- ↑ SHIDA, O.; TAKAGI, H.; KADOWAKI, K.; KOMAGATA, K. (1 October 1996). "Proposal for Two New Genera, Brevibacillus gen. nov. and Aneurinibacillus gen. nov". International Journal of Systematic Bacteriology. 46 (4): 939–946. doi:10.1099/00207713-46-4-939. ISSN 0020-7713. PMID 8863420.
- ↑ Wisotzkey, J. D.; Jurtshuk, P.; Fox, G. E.; Deinhard, G.; Poralla, K. (1 April 1992). "Comparative Sequence Analyses on the 16S rRNA (rDNA) of Bacillus acidocaldarius, Bacillus acidoterrestris, and Bacillus cycloheptanicus and Proposal for Creation of a New Genus, Alicyclobacillus gen. nov". International Journal of Systematic Bacteriology. 42 (2): 263–269. doi:10.1099/00207713-42-2-263. ISSN 0020-7713. PMID 1374624.
- ↑ Mual, Poonam; Singh, Nitin Kumar; Verma, Ashish; Schumann, Peter; Krishnamurthi, Srinivasan; Dastager, Syed; Mayilraj, Shanmugam (1 May 2016). "Reclassification of Bacillus isronensis Shivaji et al. 2009 as Solibacillus isronensis comb. nov. and emended description of genus Solibacillus Krishnamurthi et al. 2009". International Journal of Systematic and Evolutionary Microbiology. 66 (5): 2113–2120. doi:10.1099/ijsem.0.000982. ISSN 1466-5026. PMID 26907585.
- ↑ Heyndrickx, M.; Lebbe, L.; Kersters, K.; Hoste, B.; De Wachter, R.; De Vos, P.; Forsyth, G.; Logan, N. A. (1 July 1999). "Proposal of Virgibacillus proomii sp. nov. and emended description of Virgibacillus pantothenticus (Proom and Knight 1950) Heyndrickx et al. 1998". International Journal of Systematic and Evolutionary Microbiology. 49 (3): 1083–1090. doi:10.1099/00207713-49-3-1083. ISSN 1466-5026. PMID 10425765.
- ↑ "GTDB – Tree". gtdb.ecogenomic.org. Retrieved 28 May 2021.